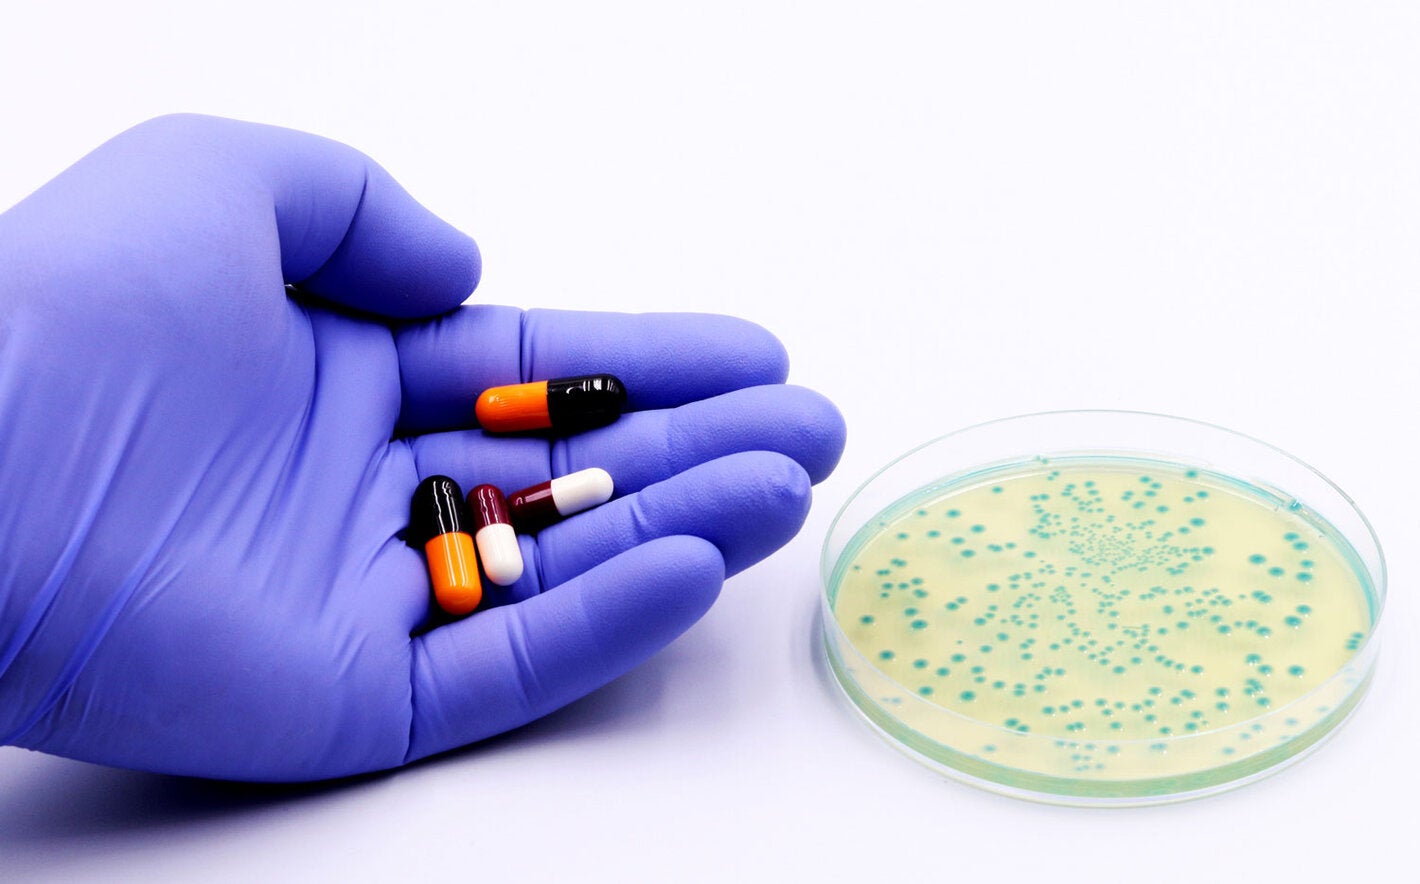
Bacteria in a Petri dish and in the hand of a doctor or researcher antibiotics or drugs.

New York, 26 September 2024 – The Pan American Health Organization (PAHO) and the Global Antibiotic Research & Development Partnership (GARDP) have signed an agreement to collaborate in the response to antimicrobial resistance (AMR) in Latin America and the Caribbean. Under the agreement, the organizations aim to improve regional antibiotic R&D, manufacturing and access in the context of the emergence and spread of antibiotic-resistant infections.
According to a study recently published in The Lancet, antimicrobial resistance contributed to 322,000 deaths in Latin America and the Caribbean in 2021. That number is expected to rise to 650,000 by 2050, placing Latin America and the Caribbean among the regions with the highest AMR mortality rates across all ages.
“The latest global estimates suggest that we are at a tipping point in the AMR crisis,” said Manica Balasegaram, Executive Director, GARDP. “If we take action now, we can avert tens of millions of deaths worldwide by 2050. R&D and access must work in tandem for a sustainable antibiotic ecosystem that serves patients in Latin America and the Caribbean and beyond.”
In line with the agreement, GARDP and PAHO will focus on advancing regional access to existing and novel antimicrobials, optimizing medicines portfolios, leveraging regional structures for improved antimicrobial access, promoting regional innovation and production of antibiotics and engaging in strategic dialogues for global R&D priorities. The agreement will also facilitate access to new products to treat serious bacterial infections including sexually transmitted infections, a significant public health concern in Latin America and the Caribbean. The partnership will collaborate with existing regional initiatives, such as PAHO’s Regional Revolving Funds for pooled procurement and the PAHO Special Program, Innovation and Regional Production Platform.
“This agreement will allow PAHO to keep pursuing universal access to the medicines and technologies needed to cure drug-resistant infections while promoting regional innovation and production of antibiotics,” PAHO Director Jarbas Barbosa said. “We know communities living in vulnerable situations in Latin America and the Caribbean are hit hardest by AMR. We must ensure fair access to the best diagnostics, treatment and prevention for all,” he added.
Leading up to the signing of this agreement, PAHO and GARDP have been working together to test the susceptibility of certain carbapenem-resistant bacteria in the region. The forthcoming findings will be used to inform optimal treatment of drug-resistant infections using certain antibiotics and to help expand regional efforts to increase access to antibiotics.
PAHO
The Pan American Health Organization (PAHO) works with the countries of the Americas to improve the health and quality of life of its population. Founded in 1902, it is the world’s oldest international public health agency. It serves as the Regional Office of WHO for the Americas and is the specialized health agency of the Inter-American system.
GARDP
We are a not-for-profit global health organization driven to protect people from the rise and spread of drug-resistant infections, one of the biggest threats to us all. By forging the public and private partnerships that matter, we develop and make accessible antibiotic treatments for people who need them. We receive vital support from the governments of Canada, Germany, Japan, Monaco, the Netherlands, Switzerland, the United Kingdom, the Canton of Geneva, the European Union, as well as the Bill & Melinda Gates Foundation, Global Health EDCTP3, GSK, the RIGHT Foundation, the South African Medical Research Council (SAMRC) and Wellcome. We are GARDP, the Global Antibiotic Research Development Partnership.



